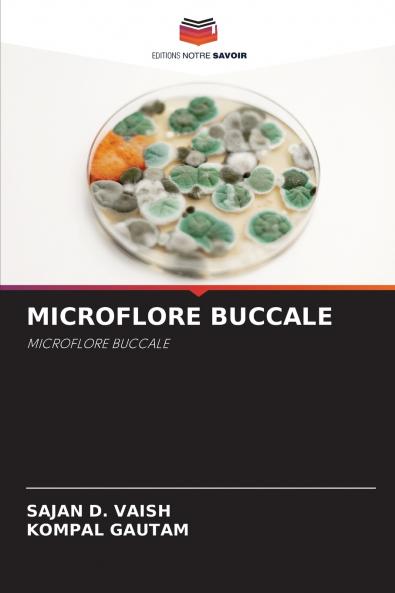
MICROFLORE BUCCALE

French
Paperback
₹6717
₹8689
22.7% OFF
(All inclusive*)
Delivery Options
Please enter pincode to check delivery time.
*COD & Shipping Charges may apply on certain items.
Review final details at checkout.
Looking to place a bulk order? SUBMIT DETAILS
About The Book
Description
Author(s)
La cavité buccale est l'un des habitats microbiens les plus complexes. Dans le corps humain la terminologie utilisée pour décrire les micro-organismes de la cavité buccale fait référence à la microflore buccale. À l'avenir il sera peut-être possible de cibler le traitement plus spécifiquement sur des agents pathogènes particuliers ou d'utiliser des approches plus imaginatives pour prévenir les maladies. Dans ce contexte les résultats de l'essai clinique actuel avec des souches de S. Mutans produisant des bactériocines non acidogènes mais faiblement compétitives seront d'une grande importance.
Delivery Options
Please enter pincode to check delivery time.
*COD & Shipping Charges may apply on certain items.
Review final details at checkout.
Details
ISBN 13
9786208220525
Publication Date
-23-10-2024
Pages
-80
Weight
-122 grams
Dimensions
-152x229x4.87 mm